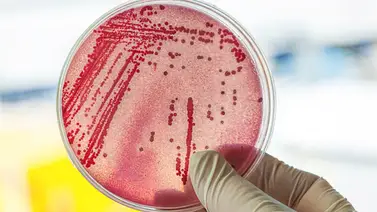

NOTAS RELACIONADAS
Actualmente, los especialistas en California se mantienen en alerta debido al incremento de los niveles de una bacteria maligna en las aguas de los ríos American y Sacramento. Por ello, las autoridades exhortan a la población a evitar bañase en dichos lugares.
En este caso, se denomina Escherichia coli, conocido como E. Coli, con un aumento significativo en el condado de Sacramento. De acuerdo a la información oficial, el origen de la contaminación proviene de varias fuentes incluyendo las aguas residuales y actividades recreativas.
Este tipo de bacteria se encuentra en los intestinos de las personas y de los animales sanos. En general, los síntomas están asociados a diarrea breve, calambres estomacales y nauseas. Los focos de infección pueden ser agua, alimentos contaminados, vegetales crudos y carne de res poco cocida.
Las autoridades de Sacramento están monitoreando de cerca la situación. También, están desarrollando campañas de concientización con el objetivo de informar a la población acerca de los riesgos y las amenazas.
Factores de riesgo
La bacteria puede afectar directamente a las personas expuestas. Sin embargo, algunos personas son más propensas a desarrollar cuadros médicos graves, entre estos:
- Edad: Las complicaciones para adultos mayores y niños pueden complicarse durante la infección.
- Sistemas inmunológicos débiles: Quienes tienen tratamientos por enfermedades crónicas tienden a tener sistemas inmunológicos más débiles que el resto.
- Tipos de alimentos: Algunos alimentos son focos importantes para la infección por E. Coli, tales como: leche, queso, hamburguesas, etc.
- Época del año: Entre junio y septiembre suelen producirse mayores infecciones por E. Coli. Hasta el momento, las razones no están claras.
- Disminución del ácido estomacal: Las personas que utilizan de manera regular los protectores gástricos, son más propensas a contraer la E. Coli.
Recomendaciones para evitar la infección de E. Coli
En este sentido, el condado de Sacramento insta a las personas a seguir una serie de recomendaciones:
- Supervisar a los niños y mascotas cerca de las aguas.
- Las personas con enfermedades preexistentes deben evitar acercarse al agua contaminada.
- Evitar el contacto directo con el agua.
- Ducharse y lavarse en las manos luego de nadar.
De igual modo, deben evitar:
- Ingerir agua del río.
- Cocinar o lavar platos en el río.
- Si presenta alguna enfermedad, no nade en el río.
- Si tiene heridas abiertas, no se bañe en las aguas del río.